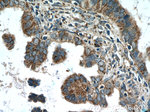
AMPK gamma2 Antibody in Immunohistochemistry (Paraffin) (IHC (P))

Search
Proteintech
AMPK gamma2 Polyclonal Antibody
{{$productOrderCtrl.translations['antibody.pdp.commerceCard.promotion.promotions']}}
{{$productOrderCtrl.translations['antibody.pdp.commerceCard.promotion.viewpromo']}}
{{$productOrderCtrl.translations['antibody.pdp.commerceCard.promotion.promocode']}}: {{promo.promoCode}} {{promo.promoTitle}} {{promo.promoDescription}}. {{$productOrderCtrl.translations['antibody.pdp.commerceCard.promotion.learnmore']}}
产品信息
12568-1-AP
种属反应
已发表种属
宿主/亚型
分类
类型
抗原
偶联物
形式
浓度
规格
纯化类型
保存液
内含物
保存条件
运输条件
产品详细信息
Immunogen sequence: EAGMLEKLE FEDEAVEDSE SGVYMRFMRS HKCYDIVPTS SKLVVFDTTL QVKKAFFALV ANGVRAAPLW ESKKQSFVGM LTITDFINIL HRYYKSPMVQ IYELEEHKIE TWRELYLQET FKPLVNISPD ASLFDAVYSL IKNKIHRLPV IDPISGNALY ILTHKRILKF LQLFMSDMPK PAFMKQNLDE LGIGTYHNIA FIHPDTPIIK ALNIFVERRI SALPVVDESG KVVDIYSKFD VINLAAEKTY NNLDITVTQA LQHRSQYFEG VVKCNKLEIL ETIVDRIVRA EVHRLVVVNE ADSIVGIISL SDILQALILT PAGAKQKETE TE (11-341 aa encoded by BC020540)
靶标信息
AMP-activated protein kinase (AMPK) is a heterotrimeric protein composed of a catalytic alpha subunit, a noncatalytic beta subunit, and a noncatalytic regulatory gamma subunit. Various forms of each of these subunits exist, encoded by different genes. AMPK is an important energy-sensing enzyme that monitors cellular energy status and functions by inactivating key enzymes involved in regulating de novo biosynthesis of fatty acid and cholesterol. This gene is a member of the AMPK gamma subunit family and encodes a protein with four cystathionine beta-synthase domains. Mutations in this gene have been associated with ventricular pre-excitation (Wolff-Parkinson-White syndrome), progressive conduction system disease and cardiac hypertrophy. Alternate transcriptional splice variants, encoding different isoforms, have been characterized.
仅用于科研。不用于诊断过程。未经明确授权不得转售。
生物信息学
蛋白别名: 5'-AMP-activated protein kinase subunit gamma-2; 5-AMP-activated protein kinase, gamma-2 subunit; ampk gamma; AMPK gamma-2 chain; AMPK gamma2; AMPK subunit gamma-2; epididymis secretory sperm binding protein; H91620p; OTTHUMP00000211956; protein kinase, AMP-activated, gamma 2 non-catalytic subunit; unnamed protein product
基因别名: 2410051C13Rik; AAKG; AAKG2; AI854673; CMH6; H91620p; PRKAG2; WPWS
UniProt ID: (Human) Q9UGJ0, (Mouse) Q91WG5
Entrez Gene ID: (Human) 51422, (Mouse) 108099